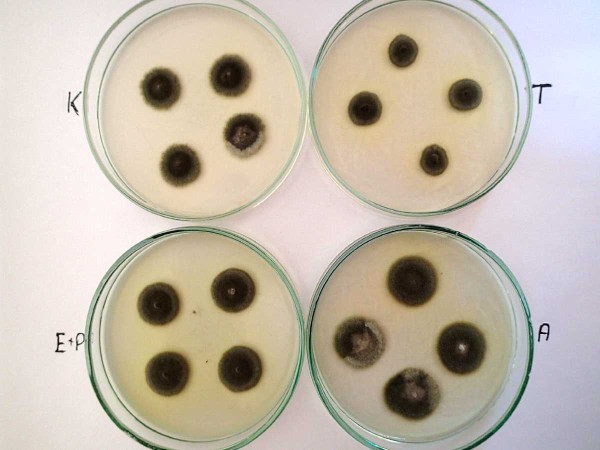
Obr. 6: Růst mycelia Cercospora beticola na živné půdě obsahující thiophanate-methyl (T), epoxiconazole a pyraclostrobin (E+P) a azoxystrobin (A), K - kontrola, živná půda bez fungicidů Obr. 6: Růst mycelia Cercospora beticola na živné půdě obsahující thiophanate-methyl (T), epoxiconazole a pyraclostrobin (E+P) a azoxystrobin (A), K - kontrola, živná půda bez fungicidů

Hlavní choroby a škůdci cukrovky v Polsku v současnosti
29. 07. 2020 Ochrana obecně Zobrazeno 833x
Cukrovku v Polsku pěstuje více než 30 600 pěstitelů na výměře více než 240 000 ha. V sezoně 2017/18 bylo dosaženo rekordního výnosu kořene 68,12 t/ha při cukernatosti 16,5 %. Průměrná velikost pěstované plodiny na pěstitele je 7,8 ha a tento průměr se v posledních letech neustále zvyšuje v důsledku ukončení pěstování u malých pěstitelů.
Tento proces je svázán s restrukturalizací polského zemědělství směrem k větším farmám. V Polsku, jako jedné ze zemí bývalého východního bloku, v období socialismu převažovala drobná zemědělská hospodářství. V nedávné minulosti a současnosti dochází postupně nárůstu velikosti zemědělských hospodářství.
Změna klimatu
V delším časovém sledu je nárůst výnosů cukrovky dán mimo jiné i změnou klimatu. Máme na mysli oteplování, kdy je možné sít cukrovku časněji a později sklízet, a tak prodloužit vegetační dobu. Lze říci, že za posledních 50 let došlo k prodloužení vegetace cukrovky až o měsíc, kdy setí se nyní začíná v březnu a maximálně do poloviny dubna je 100% cukrovky zaseté. Současně mechanizovaná sklizeň a teplé počasí na podzim umožňují prodloužení sklizně až do počátku prosince.
Samozřejmě nejvýznamnějším faktorem ovlivňujícím výnosy je množství srážek a jejich rozložení v průběhu vegetace. V 21. století lze pozorovat výrazný nárůst period sucha a počasí s vysokým stupněm slunečního záření. V souvislosti se snižujícím se obsahem zásob spodní vody, lze pozorovat častěji vadnutí porostů cukrovky, než tomu bylo v minulosti. Změny klimatu, nárůst průměrných teplot, prodloužení vegetace cukrovky, a také zákaz celé skupiny účinných látek přípravků na ochranu rostlin mají velmi výrazný vliv na výskyt chorob a škůdců cukrovky.
Na jedné straně lze pozorovat sníženou škodlivost donedávna pravidelně se vyskytujících škůdců a chorob, na druhé straně se objevují častěji noví škůdci a choroby cukrovky a to ve škodlivé míře, kdy je nutné proti nim cukrovku chránit.
Ochrana osiva
Osiva cukrovky v Polsku pocházejí od 7 osivářských firem (z čehož 2 jsou polské) a jsou mořeny fungicidně hymexazolem (Tachigaren 70 WP) a mořidlem Vibrance 30 SB (obsahuje látky fludioxonyl, metalaxyl-M, sedaxane) a insekticidně tefluthrinem (Force 20 CS). Díky výjimce lze až 30 % osiva mořit neonikotinoidy (Montur Forte 230 FS či Cruiser SB 600 FS). Takto lze mořit osiva ve firmě KHBC Kutno, která jediná v Polsku vlastní mořící linku pro semena cukrovky, která splňuje normy EFSA (European Food and Safety Agency).
Vzcházení cukrovky
Nejškodlivějším patogenem při vzcházení cukrovky je Aphanomyces cochlioides (obr. 1). Patogen se vyskytuje ve všech půdách v Polsku, kde se pěstuje cukrovka. Díky časnému setí a nižším teplotám půdy je atak patogena na rostliny cukrovky menší, protože rostliny jsou odrostlejší a méně náchylné k napadení. V roce 2019 v mnoha oblastech pěstování cukrovky však bylo možné pozorovat napadení kořenů patogenem ještě před zatažením řádků. Příčiny tohoto stavu jsou různé. Vyšší teploty a ještě dostatečná vlhkost půdy způsobily před zatažením řádků mobilitu zoospor v půdě. Vyšší podíl napadení kořenů cukrovky půdními škůdci jako důsledku omezení neonikotinoidů jako mořidel může býti příčinou vyššího napadení kořenů Aphanomyces cochlioides. Opačně však v posledních letech nejsou viditelné škody působené Pythium sp. v raných fázích vývoje řepy, a také spála působená Phoma betae a Rhizoctonia solani se objevuje výrazně méně.
V roce 2019 bylo možné sledovat významné poškození listů mladých rostlin cukrovky žírem dřepčíků Chaetocnema concina v oblasti celého Polska (obr. 2), zřejmě také v důsledku nemořeného osiva neonikotinoidy.
Podobná situace byla i případě květilky řepné (Pegomyia betae) či mšic, kdy po dlouhé době museli pěstitelé znovu použít insekticidy.
Dalším škůdcem, který v posledních třech letech působí značné ztráty na zasetých porostech cukrovky v jihovýchodní části Polska je rýhonosec řepný (Asproparthenis punctiventris, obr. 3). Tento velký brouk je zvláště škodlivý v období vzcházení cukrovky. Současně s oteplováním půdy na jaře přezimující brouci opouštějí svá zimoviště (pole, kde se v předchozím roce pěstovala řepa) a migrují do nových vzcházejících porostů. Migrace je dlouhá až 3 týdny, a proto ochrana proti škůdci je velmi obtížná. V oblastech se škodlivými výskyty rýhonosce stále pomáhají osiva na výjimku mořená neonikotinoidy a registrují se nové insekticidy, hlavně ze skupiny pyretroidů, pro aplikaci postřikem. Účinná ochrana je jedině možná kombinací agrotechnických opatření a použití insekticidů. Z agrotechnických opatření to je kultivace půdy do hloubky 20 cm, protože do této hloubky přezimuje nejvíce imag. V říjnu 2019 bylo provedeno sledování hloubky přezimování brouků a jejich početnost (tab. 1).
Dalším případem poškození listů v ranějších fázích vývoje cukrovky bude častější výskyt bakteriální skvrnitosti listů, působené bakterií Pseudomonas syringae (obr. 4). V posledních letech se s ní v Polsku potkáváme pravidelně a v roce 2019 byl její výskyt opět výraznější.
Tab. 1: Hloubka přezimování rýhonosce řepného v půdě
|
Hloubka (cm) |
Průměrný počet zimujících imag (%) |
|
do 10 |
23 |
|
10,1–20 cm |
69,2 |
|
20,1–30 |
7,8 |
|
30,1–40 |
0 |
|
Celkem |
100 % |

Obr. 1: Spála mladých rostlin způsobená Aphanomyces cochlioides

Obr. 2: Poškození listů cukrovky při vzcházení dřepčíky

Obr. 3: Samec rýhonosce řepného - diagnostika dle šikmých tmavých pásků na krovkách

Obr. 4: Bakteriální skvrnitost listů cukrovky (Pseudomonas syringae)
Hniloby kořenů
Hniloby kořenů jsou pravidelně působené patogeny Aphanomyces cochlioides (obr. 5) nebo Rhizoctonia solani. Choroby se vyskytují na jednotlivých rostlinách či v ohniscích, málokdy dochází k plošnému poškození. Výskyty jsou zatím sporadické, v závislosti na podmínkách počasí a na kyselých půdách s pH nižším než 5,5.
V posledních letech nebyly pozorovány rostliny poškozené na kořenech patogenem Fusarium oxysporum.

Obr. 5: Kořen cukrovky napadený Aphanomyces cochlioides v pozdější fázi vegetace
Cerkosporová listová skvrnitost
V minulých letech z řepných polí prakticky zmizely škodlivé výskyty patogenů jako Peronospora beticola, Erysiphe betae, Ramularia beticola i Uromyces betae. Sporadicky se ale mohou vyskytnout.
Tento nízký výskyt je způsoben intenzivní fungicidní ochranou proti hlavnímu patogenu listů cukrovky houbě Cercospora beticola. Napadení cerkosporovou listovou skvrnitostí každoročně působí velké škody na výnosech kořene i cukernatosti. Největší napadení je v oblastech jižního a jihovýchodního Polska, nižší napadení je v severozápadních oblastech pěstování cukrovky. Udržet napadení pod kontrolou je rok od roku složitější a je nutná stále intenzivnější ochrana. V tab. 2 je uvedeno, jak se choroba vyvíjí v čase a v jednotlivých pěstitelských oblastech Polska. Doporučení pro pěstitele je začít ochranu fungicidy co nejdříve po zjištění prvních příznaků napadení na listech a další postřik provést po 3 týdnech.
Preventivní ochrana je málo uplatňována a opírá se především o sledování průběhu vhodných povětrnostních podmínek pro šíření patogena. S ohledem na prodlužování vegetace a vysoké teploty ke konci léta, se často ochrana provádí ještě v polovině září.
V Polsku od konce minulého století lze pozorovat změny v populacích Cercospora beticola a nárůst kmenů patogena s rezistencí vůči účinným látkám fungicidů (obr. 6). První případ rezistence byl zjištěn u látky benzimidazole. V Polsku je patogen rezistentní vůči thiophanate-methylu, ale pokud jsou užívány přípravky s více účinnými látkami, kde tento přípravek je také obsažen, tak tyto přípravky zatím fungují. Nejvíce se v Polsku používají triazoly, a to hlavně epoxiconazole, méně difenoconazole a tebuconazole. Rezistence bývá zjišťovánav oblastech, ve kterých se používá nejvíce ochranných zásahů. V centrální části Polska se aplikace fungicidů omezily kvůli nižším výskytům Cercospora beticola z důvodu sucha a kmeny patogena z těchto oblastí vykazují také nižší úroveň rezistence. Nejméně rezistentních kmenů patogena bylo zatím zjištěno u difenoconazolu, protože tato látka byla introdukována v Polsku teprve v roce 2016 a v krátké době jeho užití se zatím rezistentní kmeny výrazně nevyselektovaly. Další skupinou účinných látek používaných proti Cercospora beticola jsou strobiluriny. Velmi rychle vzrůstá podíl rezistentních kmenů na azoxystrobin a pyraclostrobin aobecně je v Polsku až 50 % testovaných izolátů rezistencích vůči strobilurinům (tab. 3).
V reakci na tato zjištění je nutné dodržovat antirezistentní strategii ochrany se střídáním látek s různým mechanizmem účinku. K posílení této strategie by měly být zaregistrovány do cukrovky měďnaté přípravky. Jejich užití ve směsi by mělo omezit přežívání izolátů rezistentních vůči systémově působícím látkám.
Tab. 2: Změny v termínu prvních výskytů Cercospora beticola a počet ochranných zásahů fungicidy v různých oblastech Polska
|
Období |
Jihovýchodní Polsko |
Severní Polsko |
||
|
první výskyty |
počet ochranných zásahů |
první výskyty |
počet ochranných zásahů |
|
|
80. léta 20. století |
srpen |
0–1 |
září |
0 |
|
Počátek 21. století |
počátek až polovina července |
1–2 (někdy až 3) |
počátek až polovina srpna |
1 |
|
Současnost |
polovina června, počátek července |
3–5 |
konec července, počátek srpna |
1–2 |
Tab. 3: Průměrný podíl rezistentních izolátů Cercospora beticola vůči účinným látkám fungicidů v Polsku v roce 2018
|
Region Polska |
Rezistence testovaných izolátů (% ) |
|||
|
thiophanate-methyl* |
azoxystrobin |
epoxiconazole |
difenoconazole |
|
|
Jihovýchod |
96 |
54 |
31 |
11 |
|
Centrální oblast |
95 |
39 |
6 |
3 |
|
Severozápad |
92 |
67 |
13 |
13 |
|
Pozn.: * údaje z roku 2016 |
||||
Obr. 6: Růst mycelia Cercospora beticola na živné půdě obsahující thiophanate-methyl (T), epoxiconazole a pyraclostrobin (E+P) a azoxystrobin (A), K - kontrola, živná půda bez fungicidů
Škůdci během vegetace
Vážným problémem se v poslední době stávají škůdci v pozdějších fázích vegetace cukrovky.
V souvislosti s oteplením klimatu narůstá výskyt můr (Noctuidae), a také se mění jejich druhové spektrum. Obecně proti můrám nejsou v Polsku zaregistrovány insekticidy.
V posledních deseti letech výrazně vzrostla škodlivost svilušky chmelové (Tetranychus urticae) v cukrovce. Sviluška nejvíce škodí v jihovýchodním a centrálním Polsku. Sání tohoto škůdce vede ke žloutnutí listů, rozsáhlým nekrózám až zasychání a dochází k velkým ztrátám na výnosech. Jediným preparátem registrovaným proti svilušce je v Polsku fenpiroxymate (Ortus 05 SC).
V posledních dvou letech dochází z jihu k migraci makadlovky řepné (Scrobipalpa ocellatella, obr. 7). Na jihu Polska byly již zaznamenány škodlivé výskyty a pozorování na polích v Dolním Slezsku v první dekádě října 2019 potvrdily výskyty téměř na všech sledovaných porostech. V okolí Wroclawi bylo zaznamenáno až 80% napadení srdéčkových listů. Makadlovka působila škodlivě též v okolí Poznaně. Při přetrvávajících klimatických změnách - výrazném suchu a vysokých teplotách v červenci a srpnu, dojde zřejmě k dalšímu rozšíření škůdce do všech oblastí Polska, kde se pěstuje cukrovka. I u tohoto škůdce chybí oficiálně registrované insekticidy.
Stejně jako v dalších zemích EU i v Polsku se začíná objevovat problém s nedostatkem vhodných přípravků na ochranu rostlin proti škůdcům. Pěstitelé mají obecně k dispozici dimethoate (do konce června 2020), thiacloprid (do konce února 2021) a pyretroidy. V roce 2021 budou k dispozici již jen pyretroidy, a to nezabezpečí dostatečnou ochranu porostů před škůdci. Kromě přímých škod žírem a sáním škůdců, vzrostou i škody nepřímé, jako v případě vyššího výskytu virových žloutenek a virové mozaiky řepy přenosných mšicemi. Tyto virové choroby cukrovky díky neonikotinoidům z polí v minulosti prakticky zmizely.

Obr. 7: Housenka makadlovky řepné (Scrobipalpa ocellatella)
Souhrn
Ochrana porostů cukrovky v době značného oteplení klimatu a v době zákazu použití řady účinných látek přípravků na ochranu rostlin je čím dále tím více těžším úkolem jak pro pěstitele, tak i zpracovatele cukrovky. Tato skutečnost klade nové náročné úkoly pro vědu a výzkum, kdy se objevují nové problémy, jejichž řešení často velmi spěchá.
Prof. dr. Jacek Piszczek; IOR-PIB (Institut ochrany rostlin) Poznan, Polsko
Prof. dr. ZdzisławKlukowski; UP (Přírodovědecká univerzita) Wrocław, Polsko
Překlad: Ing. Vít Bittner
Další články v kategorii Ochrana obecně











RSS
RSS